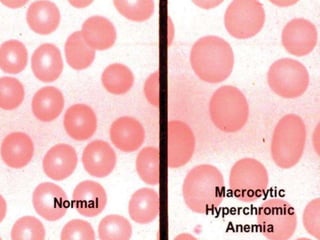
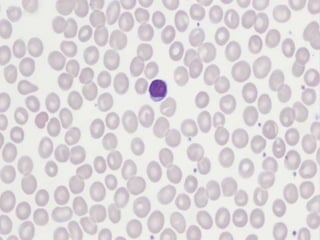
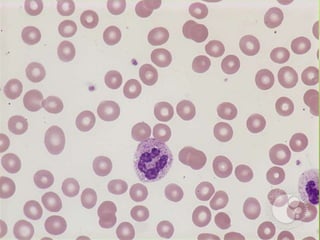

This document provides an overview of anemia presented by Muhammad Abbas. It defines anemia as a decrease in hemoglobin below normal levels and discusses the pathophysiology and classification of anemia. Anemia is classified clinically based on severity, etiologically based on cause, and morphologically based on mean corpuscular volume. The main types are microcytic hypochromic anemia, macrocytic hyperchromic anemia, and normocytic normochromic anemia. Causes and diagnostic investigations for each type are also outlined.